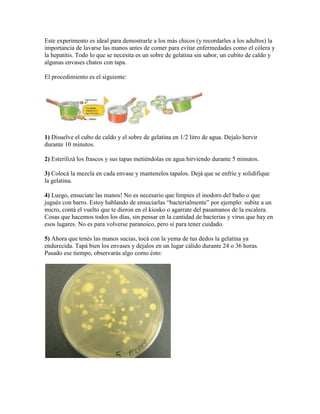
Criadero De Insectos

Incrustar presentación
Descargado 21 veces







Este documento presenta tres experimentos sobre el desarrollo de plantas. El primero muestra cómo girar continuamente una rueda con semillas de lenteja simula diferentes niveles de gravedad y permite observar cómo afecta la gravedad al crecimiento de las plantas. El segundo experimento usa tubos con glicerina y bolas metálicas para explicar cómo las auxinas de la planta responden a la rotación. El tercero propone usar gelatina y bacterias para demostrar la importancia del lavado de manos.